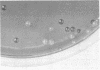
40

Abstract
A medium containing trypan blue, gentamicin, and chloramphenicol is introduced for the detection of Cryptococcus neoformans and Cryptococcus species from clinical samples. Ten recently isolated strains of Cryptococcus species as well as several clinical isolates of C. neoformans incorporated trypan blue and produced dark blue colonies on this mycological medium, whereas other common yeasts were light blue. The laboratory diagnosis of two cases of cryptococcosis was accomplished by the isolation of C. neoformans on the antibiotic-dye-containing medium. Compared to conventional media supporting large numbers of Pseudomonas aeruginosa and other gram-negative bacilli, the new medium was selective for yeasts. In one instance, the colonization of the respiratory tract by C. neoformans which led to fungemia was traced by the use of the antibiotic-dye medium. The antibiotic mixture, utilized herein, was more effective in suppressing bacteria contained in samples from patients than a medium containing cycloheximide and chloramphenicol.
Full text
PDF




Images in this article
Selected References
These references are in PubMed. This may not be the complete list of references from this article.
- Dolan C. T. Optimal combination and concentration of antibiotics in media for isolation of pathogenic fungi and Nocardia asteroides. Appl Microbiol. 1971 Feb;21(2):195–197. doi: 10.1128/am.21.2.195-197.1971. [DOI] [PMC free article] [PubMed] [Google Scholar]
- Finland M. Gentamicin: antibacterial activity, clinical pharmacology and clinical applications. Med Times. 1969 Dec;97(12):161–174. [PubMed] [Google Scholar]
- GEORG L. K., AJELLO L., PAPAGEORGE C. Use of cycloheximide in the selective isolation of fungi pathogenic to man. J Lab Clin Med. 1954 Sep;44(3):422–428. [PubMed] [Google Scholar]
- Gilbert D. N., Kutscher E., Ireland P., Barnett J. A., Sanford J. P. Effect of the concentrations of magnesium and calcium on the in-vitro susceptibility of Pseudomonas aeruginosa to gentamicin. J Infect Dis. 1971 Dec;124 (Suppl):S37–S45. doi: 10.1093/infdis/124.supplement_1.s37. [DOI] [PubMed] [Google Scholar]
- NICKERSON W. J., MANKOWSKI Z. A polysaccharide medium of known composition favoring chlamydospore formation in Candida albicans. J Infect Dis. 1953 Jan-Feb;92(1):20–25. doi: 10.1093/infdis/92.1.20. [DOI] [PubMed] [Google Scholar]
- Shields A. B., Ajello L. Medium for selective isolation of Cryptococcus neoformans. Science. 1966 Jan 14;151(3707):208–209. doi: 10.1126/science.151.3707.208. [DOI] [PubMed] [Google Scholar]